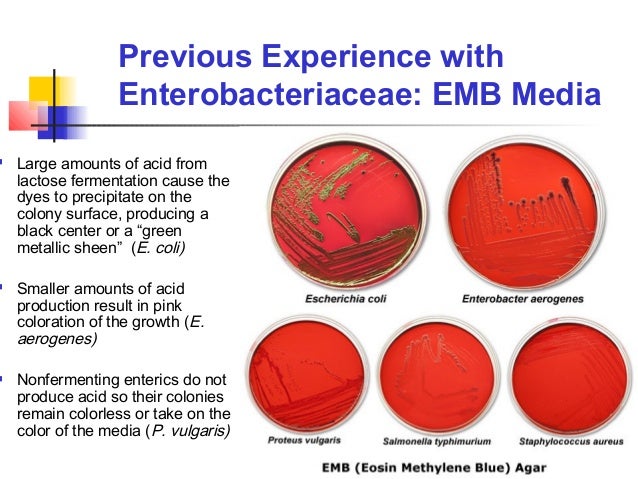
Biochem2 (1)

If you are looking for Biochem2 (1) you've came to the right page. We have 9 Pictures about Biochem2 (1) like Towards Cell Scale Molecular Dyamics - K. Schulten, July 2012, Biochemical tests for identification of bacteria and also Gram staining. Here it is:
Biochem2 (1)
www.slideshare.net
www.slideshare.net biochem2
Why It Matters: The Immune System | Biology For Majors II
 courses.lumenlearning.com
courses.lumenlearning.com majors
The Winogradsky Column
 www.slideshare.net
www.slideshare.net winogradsky clostridium biochemistry anaerobic
PPT - Bacteria Characteristics PowerPoint Presentation, Free Download
 www.slideserve.com
www.slideserve.com bacteria characteristics environments thrive extreme ppt powerpoint presentation archaebacteria kingdom salty thermophiles methane halophiles methanogens anaerobic
Animal Cell Culture Techniques
 www.slideshare.net
www.slideshare.net Biochemical Tests For Identification Of Bacteria
 www.slideshare.net
www.slideshare.net biochemical tests
Gram Staining
 es.slideshare.net
es.slideshare.net Towards Cell Scale Molecular Dyamics - K. Schulten, July 2012
 www.slideshare.net
www.slideshare.net photosynthesis dyamics schulten molecular photosynthetic
Biological Freak: 改寫演化史的兩種微生物:藍綠藻與紫色細菌 10-14-2018
 biologicalfreak.blogspot.com
biologicalfreak.blogspot.com Gram staining. Photosynthesis dyamics schulten molecular photosynthetic. Towards cell scale molecular dyamics